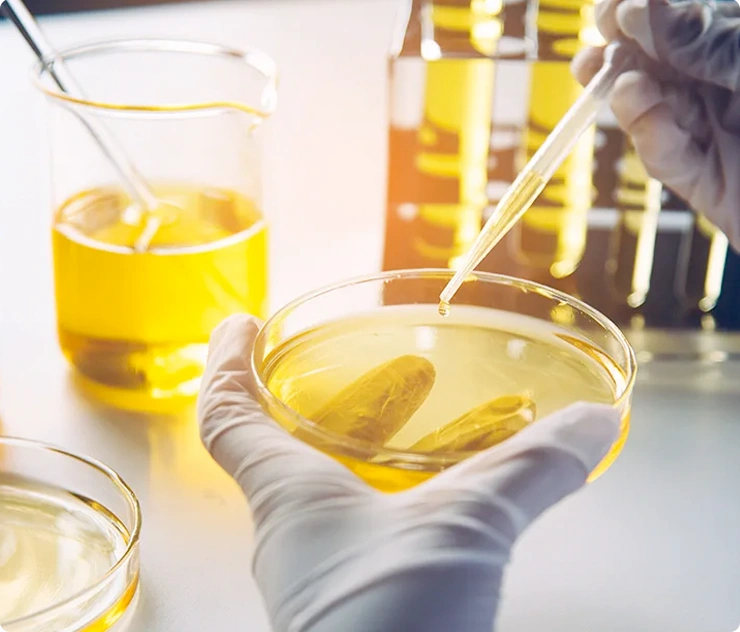

SERVICIOS
* Consultoría.
* Diseño y montaje de líneas de producción.
* Pruebas y Desarrollos.
* Maquilas de materias primas.
* Trámites ante invima.


CONSULTORÍA
Podemos asesorar su proyecto ofreciendo soluciones y maquinarias diseñadas para el procesamiento de semillas oleaginosas y otras materias primas que brinden el máximo valor a emprendedores y operadores. Comuníquese con nosotros si tiene preguntas sobre cómo podemos apoyar su proyecto de semillas oleaginosas y otros relacionados con la Agroindustria.
Contamos con amplio conocimiento en procesos y maquinaria, estamos prestos para que cualquier persona o institución con fines empresariales, académicos o de otro carácter que deseen aprender, incursionar o innovar en el procesamiento de semillas oleaginosas y de otros sectores de la economía.
PRUEBAS Y DESARROLLOS
Podemos proporcionar valor a su proyecto o idea de negocio en la fase inicial o intermedias de desarrollo mediante la realización de ensayos, pruebas, orientación y capacitación en la elaboración de aceites y otros productos relacionados con la Agroindustria; póngase en contacto con nosotros, pregunte sobre cómo podemos apoyar su proyecto, puede traer, enviar materias primas, semillas y otras materias primas. Infórmenos cuál es su necesidad para que podamos agregar valor a sus emprendimientos.
Este es un servicio útil si desea verificar el rendimiento probable, la calidad de la prueba o presentar muestras a sus clientes potenciales.
Aseguramos a nuestros clientes actuales y potenciales un alto nivel de secreto industrial.

MAQUILA DE MATERIAS PRIMAS
Estamos en capacidad de procesar diversos tipos de semillas para obtención de aceites vegetales y otros subproductos (tortas que pueden ser convertidas en harina) para uso como materia prima o que sean usados como ingrediente intermedio para la elaboración de alimentos o cosméticos que posteriormente se comercialicen para la venta directa al público.
TRAMITES ANTE INVIMA
Asesoramos y gestionamos en aspectos técnicos exigidos por el Instituto nacional de vigilancia de medicamentos y alimentos INVIMA para adelantar con éxito el diligenciamiento y la consecución de su PERMISO o REGISTRO SANITARIO para aceites, snacks, harinas y otros alimentos a partir de semillas oleaginosas.

